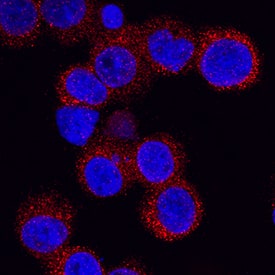
Intelectin-1/Omentin antibody in U937 Human Cell Line by Immunocytochemistry (ICC).

Human Intelectin-1/Omentin Antibody
R&D Systems, part of Bio-Techne | Catalog # AF4254


Key Product Details
Species Reactivity
Validated:
Cited:
Applications
Validated:
Cited:
Label
Antibody Source
Product Specifications
Immunogen
Thr19-Ser298
Accession # Q8WWA0
Specificity
Clonality
Host
Isotype
Scientific Data Images for Human Intelectin-1/Omentin Antibody
Intelectin-1/Omentin in Mouse Intestine.
Intelectin-1/Omentin was detected in immersion fixed frozen sections of mouse intestine using 10 µg/mL Sheep Anti-Human Intelectin-1/Omentin Antigen Affinity-purified Polyclonal Antibody (Catalog # AF4254) overnight at 4 °C. Tissue was stained with the NorthernLights™ 557-conjugated Anti-Sheep IgG Secondary Antibody (red; NL010) and counterstained with DAPI (blue). View our protocol for Fluorescent IHC Staining of Frozen Tissue Sections.Intelectin‑1/Omentin in U937 Human Cell Line.
Intelectin-1/Omentin was detected in immersion fixed U937 human histiocytic lymphoma cell line using Sheep Anti-Human Intelectin-1/Omentin Antigen Affinity-purified Polyclonal Antibody (Catalog # AF4254) at 5 µg/mL for 3 hours at room temperature. Cells were stained using the NorthernLights™ 557-conjugated Anti-Sheep IgG Secondary Antibody (red; NL010) and counterstained with DAPI (blue). Specific staining was localized to cytoplasm. View our protocol for Fluorescent ICC Staining of Cells on Coverslips.Detection of Human Intelectin-1/Omentin by Immunocytochemistry/Immunofluorescence
SPINK4 and ITLN1 mark early goblet cells. a Volcano plot showing fold change and P value of genes differentially expressed in the ‘goblet-type’ cell cluster as compared to all other cell clusters (see Fig. 3). Points coloured red indicate genes significant at 5% permutation test. Selected highly significant genes are labelled. b Bar chart showing the percentage of cells in the ‘goblet-type’ cell cluster (n = 98) expressing MUC2, ITLN1 or SPINK4 alone or in different combinations (thresholds set at the tenth centile to include 90% of cells in which at least one transcript was detected from each gene). c Triple immunofluorescence staining images of MUC2 (red), ITLN1 (white) and SPINK4 (green) in normal colon from a resection specimen (blue stain is DAPI). Scale bar, 100 µm. d Triple immunofluorescence staining images of MUC2 (red), ITLN1 (white) and SPINK4 (green) in normal oesophageal epithelium obtained by endoscopic biopsy (blue stain is DAPI). OSGs encroaching on the surface epithelium are shown in the enlarged images on the right. Scale bars are 200 µm and 50 µm in enlarged images. e Triple immunofluorescence staining images of KRT14 (white), KRT7 (green) and MUC2 (red) in an OSG beneath normal squamous epithelium from an endoscopic biopsy of normal squamous epithelium from a patient with BO biopsy (blue stain is DAPI). Scale bar 50 µm. f Representative immunofluorescence staining of Barrett’s EMR specimen containing intestinal metaplasia but no dysplasia for MUC2 (red), ITLN1 (white) and SPINK4 (green); nuclei (DAPI) in blue. Scale bars are 400 µm and 100 µm in enlarged images Image collected and cropped by CiteAb from the following publication (https://pubmed.ncbi.nlm.nih.gov/30323168), licensed under a CC-BY license. Not internally tested by R&D Systems.Applications for Human Intelectin-1/Omentin Antibody
Immunocytochemistry
Sample: Immersion fixed U937 human histiocytic lymphoma cell line
Immunohistochemistry
Sample: Immersion fixed frozen sections of mouse intestine
Western Blot
Sample: Recombinant Human Intelectin-1/Omentin
Formulation, Preparation, and Storage
Purification
Reconstitution
Formulation
Shipping
Stability & Storage
- 12 months from date of receipt, -20 to -70 °C as supplied.
- 1 month, 2 to 8 °C under sterile conditions after reconstitution.
- 6 months, -20 to -70 °C under sterile conditions after reconstitution.
Background: Intelectin-1/Omentin
Intelectin-1 (intestinal lectin; also ITLN-1 and omentin) is a 40 kDa Ca-dependent galactofuranose-binding lectin that is not a C-type lectin. It is expressed on multiple cell types and appears to participate in insulin signaling and microbe recognition. The human ITLN-1 preproprecursor is 313 amino acids (aa) in length. It contains an 18 aa signal sequence, a 280 aa mature segment (aa 19-298), and a 15 aa C-terminal proregion that is cleaved to generate a GPI-linkage. One fibrinogen-related domain exists in the mature molecule (aa 36-209). Human ITLN-1 exists as a disulfide-linked glycosylated homotrimer. Mouse ITLN-1 is unglycosylated and a monomer. Mature human ITLN-1 is 82% aa identical to mouse ITLN-1. Human ITLN-1 shows one alternate start site at Met72, and a splice form that contains a 32 aa substitution for aa 264-313.
Alternate Names
Gene Symbol
UniProt
Additional Intelectin-1/Omentin Products
Product Documents for Human Intelectin-1/Omentin Antibody
Product Specific Notices for Human Intelectin-1/Omentin Antibody
For research use only